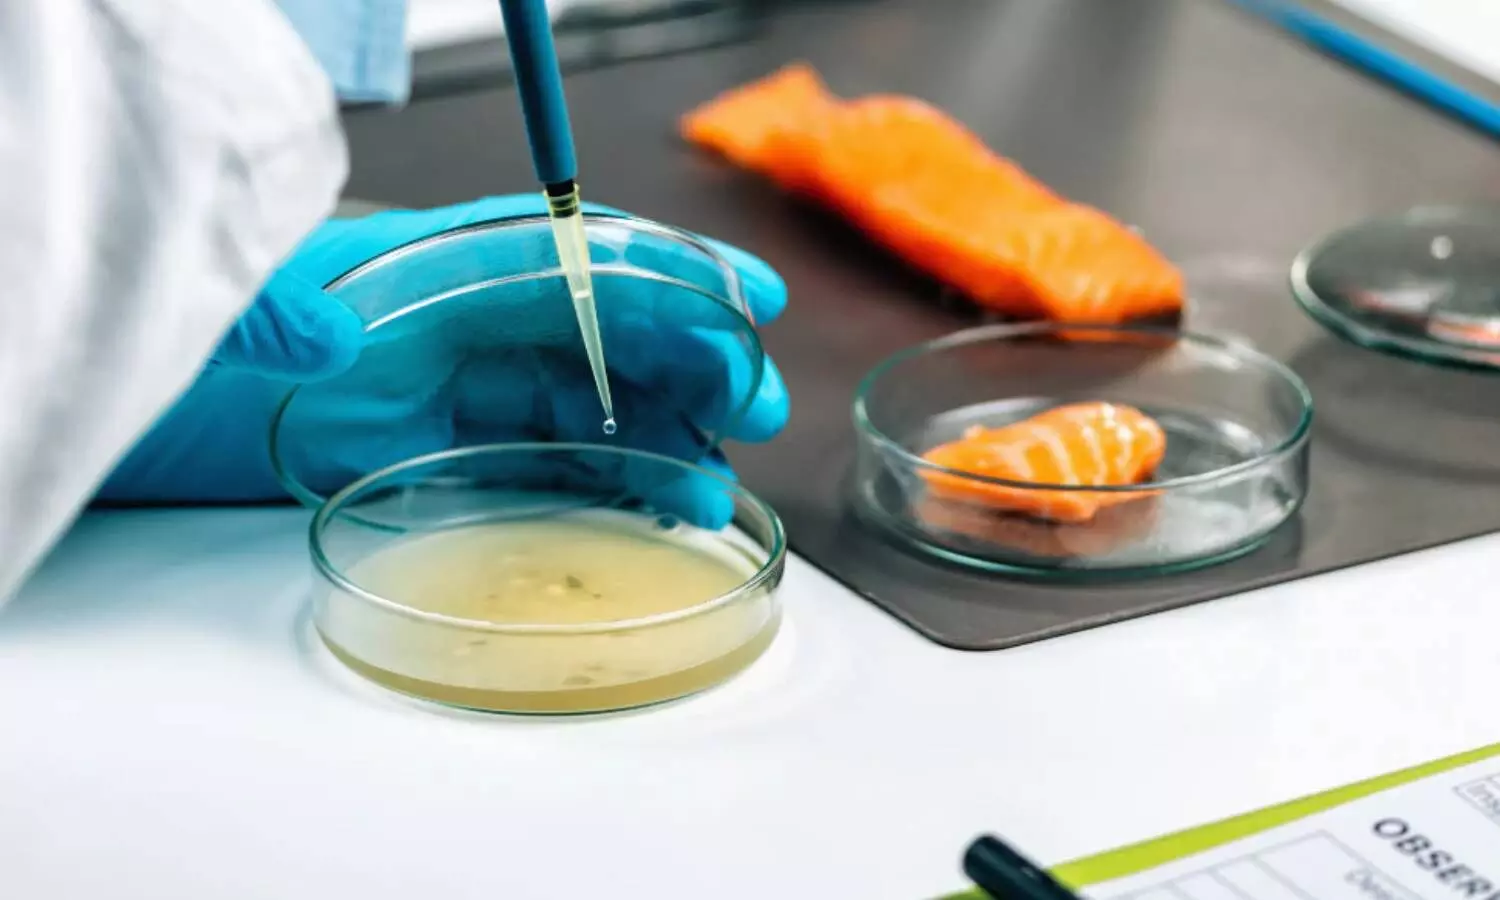

केरल: राज्य मंत्री जॉर्ज कुरियन कोच्चि में अत्याधुनिक खाद्य परीक्षण प्रयोगशाला का करेंगे उद्घाटन
केंद्रीय मत्स्य पालन, पशुपालन और डेयरी राज्य मंत्री जॉर्ज कुरियन शनिवार को कोच्चि में अत्याधुनिक खाद्य परीक्षण प्रयोगशाला का उद्घाटन करेंगे. यह केरल के डेयरी और खाद्य क्षेत्रों के लिए गुणवत्ता आश्वासन बुनियादी ढांचे को मजबूत करने की दिशा में एक महत्वपूर्ण कदम है.यह सुविधा मिल्मा (केरल कोऑपरेटिव मिल्क मार्केटिंग फेडरेशन लिमिटेड) और राष्ट्रीय डेयरी विकास बोर्ड (एनडीडीबी) के बीच सहयोग से स्थापित की गई है.
डेयरी उद्योग की परीक्षण आवश्यकताओं को पूरा करेगी
एनडीडीबी सीएएलएफ (पशुधन और खाद्य विश्लेषण और शिक्षण केंद्र) लिमिटेड के तहत स्थापित यह प्रयोगशाला, एडप्पल्ली में एर्नाकुलम क्षेत्रीय सहकारी दुग्ध उत्पादक संघ (ईआरसीएमपीयू) परिसर में स्थित है. कोच्चि स्थित यह सुविधा एनडीडीबी सीएएलएफ लिमिटेड की एक शाखा के रूप में कार्य करेगी और देश भर में एनडीडीबी की अन्य प्रयोगशालाओं द्वारा अपनाए जाने वाले समान कड़े पेशेवर और गुणवत्ता मानकों का पालन करेगी.
यह प्रयोगशाला शुरुआती चरण में मुख्य रूप से केरल और पड़ोसी राज्यों में डेयरी उद्योग की परीक्षण आवश्यकताओं को पूरा करेगी, जिसमें दूध और दूध के उत्पादों की व्यापक गुणवत्ता और सुरक्षा परीक्षण के लिए पहले से ही सुविधाएं मौजूद हैं.ईआरसीएमपीयू के अध्यक्ष सीएन वलसलान पिल्लई के मुताबिक, प्रयोगशाला की सेवाओं का दायरा चरणबद्ध तरीके से बढ़ाया जाएगा ताकि इसमें मसाले, फल, सब्जियां, बेकरी उत्पाद, रेडी-टू-ईट खाद्य पदार्थ, मछली और संबंधित उत्पादों जैसी खाद्य और कृषि वस्तुओं का परीक्षण शामिल हो सके.
इस प्रयोगशाला को नेशनल एक्रेडिटेशन बोर्ड फॉर टेस्टिंग एंड कैलिब्रेशन लैबोरेटरीज (एनएबीएल), नई दिल्ली से मान्यता प्राप्त है, जो राष्ट्रीय स्तर पर मान्यता प्राप्त परीक्षण मानकों के अनुपालन को सुनिश्चित करती है. एनडीडीबी सीएएलएफ के प्रबंध निदेशक डॉ. राजेश नायर ने कहा कि आधुनिक बुनियादी ढांचे और उन्नत उपकरणों से सुसज्जित कोच्चि प्रयोगशाला खाद्य सुरक्षा जोखिमों को कम करने के उद्देश्य से वैज्ञानिक परीक्षण सेवाएं प्रदान करके राज्य सरकार के विभागों और खाद्य सुरक्षा प्राधिकरणों को भी सहयोग प्रदान करेगी.
एनडीडीबी सीएएलएफ लिमिटेड, एनडीडीबी की पूर्ण स्वामित्व वाली सहायक कंपनी है, जिसका मुख्यालय गुजरात के आनंद में स्थित है. यह कंपनी 17 वर्षों से अधिक समय से डेयरी, खाद्य और कृषि क्षेत्रों के साथ-साथ नियामक प्राधिकरणों को विश्लेषणात्मक परीक्षण, अनुसंधान और सलाहकार सेवाएं प्रदान कर रही है.
Input IANS


